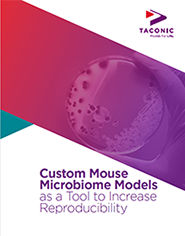

The influence of the microbiome is redefining drug discovery in nearly every area of research, and Taconic Biosciences is leading the way. As the only comprehensive provider of microbiome products and services, and with over 50 years of experience in the field, Taconic's microbiome platform is an essential resource for any drug discovery program.
Prepare Your Model
Microbiome Solutions and Germ-Free Mice
“Seres relies on Taconic's germ-free mice to study the microbiome and our drug candidates.”
– Seres Therapeutics
“Federation Bio utilizes Taconic's germ-free mouse models to advance our pre-clinical research programs. As an early stage microbiome biotech company, Taconic has been a valuable partner in our pre-clinical research.”
– Federation Bio
Applicable Areas of Research
- Microbiology
- Physiology
- Immunology
- Metabolism
- Oncology and Immuno-Oncology
- Neurological Disorders
- Inflammatory Bowel Disease
Learn more about Taconic's microbiome solutions and germ-free mice:
Get In Touch
Book a complimentary consultation or get support for an existing order
If you need immediate assistance, please contact Customer Service:
Taconic Corporate Offices
Email: info@taconic.com
Phone: +1 (518) 697-3900
273 Hover Ave., Germantown, NY 12526
North American Customer Service
Email: info@taconic.com
Phone: +1 (518) 697-3915
Toll-free: +1 (888) 822-6642
Hours: (Monday - Friday): 7 a.m. - 6 p.m. ET
European Customer Service
Email: info@taconic.com
Phone (Europe and Denmark): +45 70 23 04 05
Phone (Germany): +49 214 50 68 023
Hours: (Monday - Friday): 7 a.m. - 5 p.m. CET
Microbiome Solutions
Have Questions About Microbiome Solutions and Germ-Free Mice or Ready to Submit Samples?
Featured Content

















.jpg)

.jpg)
.jpg)
.jpg)
.jpg)





.jpg)


.jpg)
.jpg)




.jpg)





.jpg)

.jpg)